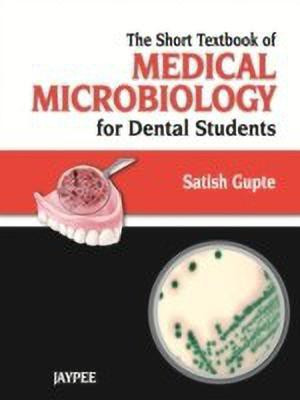

Short Textbook of Medical Microbiology for Dental Students(English, Paperback, Gupte Satish)
Quick Overview
Product Price Comparison
Comprised of eight sections (General Bacteriology, Immunology, Systemic Bacteriology, Oral Microbiology, Virology, Mycology, Parasitology, and Clinical Microbiology), this invaluable book includes everything dental students need to pass their medical microbiology exam.Coloured simplified diagrams, multi-coloured photographs, tables and illustrations are incorporated at relevant areas of the book.Includes a dedicated section on Oral Microbiology covering a general outline, treatment and prevention of various infections of oral/dental infections.Various oral infections are discussed ranging from dental caries, periodontal infections to oral mucosal and systemic infections.The topics like cleaning, disinfection and sterilization in dental surgery are also included.Enriches with information on latest issues like HIV, Swine flu, hepatitis, bird flu, SARS, and biofilm, etc.